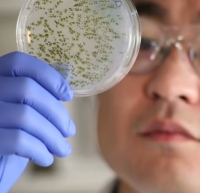

Pesquisadores encontraram mutações nos genes associados aos cânceres de mama e de ovário ( BRCA1 e BRCA2) em um número significativo de homens com câncer de próstata avançado. É o que diz um estudo publicado no periódico científico Cell.
Ao analisarem o DNA do tecido tumoral de 150 homens com câncer de próstata em estágio avançado, os estudiosos revelaram mutações destes genes em cerca de 15% dos casos. De acordo com os autores do estudo, essa é uma descoberta que pode conduzir a novos tratamentos para os homens com a doença. Estudos anteriores já haviam identificado a relação, mas em número muito inferior.
A descoberta sugere que cerca de 20% dos homens que pararam de responder ao tratamento convencional (terapia hormonal) podem ser candidatos para uma nova classe de medicamentos.
Os pesquisadores, no entanto, identificaram uma caracteristica especial nos tumores masculinos. Diferentemente do que ocorre com os cânceres de mama e de ovário, quando as mutações dos genes BRCA1 e BRCA2 são tipicamente hereditárias, as mutações encontradas nos pacientes com câncer de próstata avançado surgem espontaneamente durante o desenvolvimento da doença.
"O passo foi grande, mas ainda são necessários estudos clínicos mais aprofundados para confirmar se as condutas médicas utlizadas com os homens serão as mesmas que hoje se aplica às mulheres", afirmou Charles Sawyers, presidente do Programa de Oncologia e Patogênese Humana do Centro de Câncer Memorial Sloan Kettering e um dos líderes do trabalho.